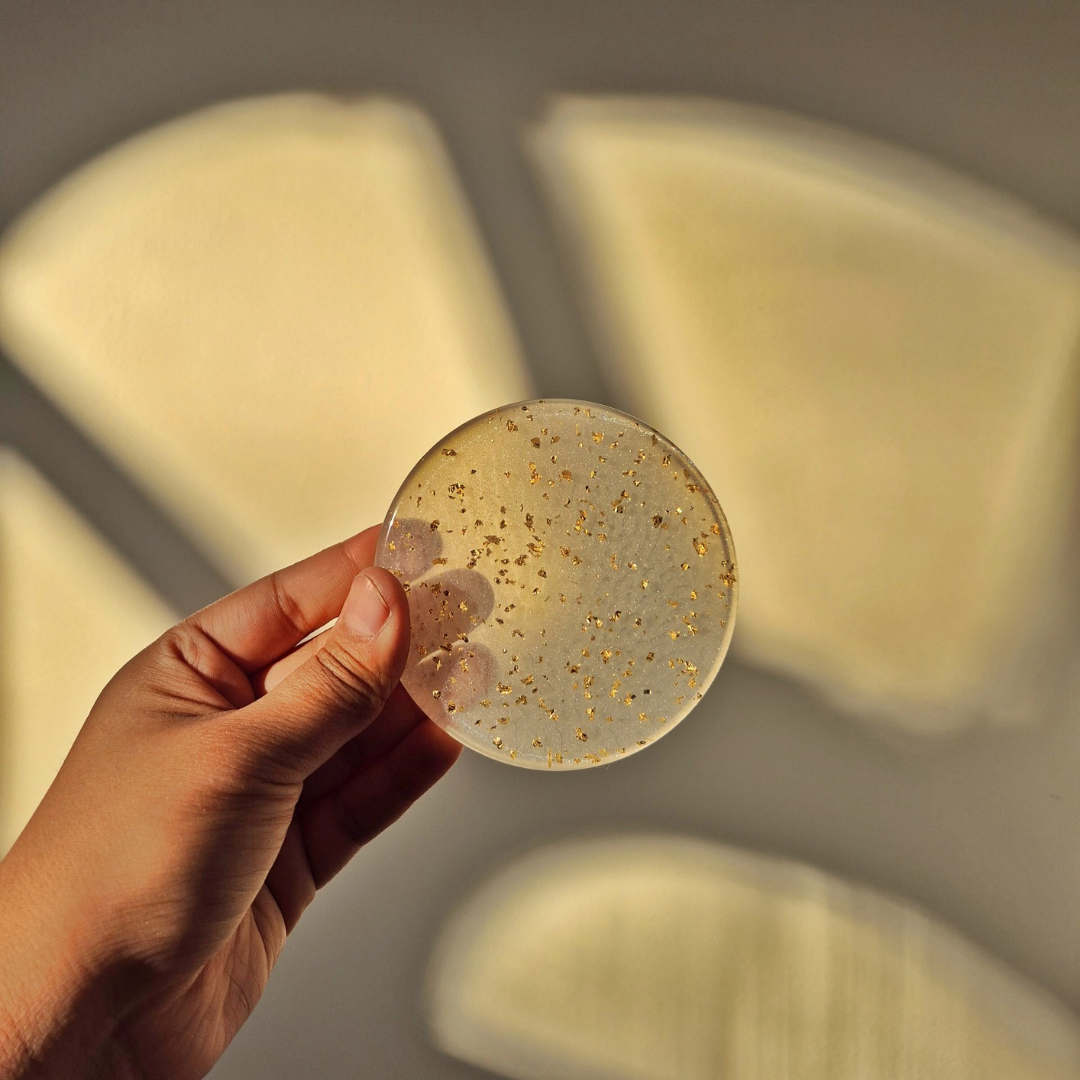

1
/
of
1
Gold flakes resin coasters
Gold flakes resin coasters
Regular price
Rs. 399.00
Regular price
Sale price
Rs. 399.00
Unit price
/
per
Shipping calculated at checkout.
Couldn't load pickup availability
-For 1 coaster
-Price inclusive of all taxes
-Made to order
-Exquisite, glass finish
-Made with premium quality resin
-Processing time: 10 days
-Use with care
-Clean with a dry or damp cloth only
- Fast Shipping
- Eco-conscious
- Bespoke
-
Handmade with love
-
Get your order customized
-
Packaged with care
-
One of a kind
Made by us, loved by you
-
Add a bit of oomph to your dinner dates with our bestseller Ghazal danglers
-
Casual, chic lockets for all your last-minute plans
-
Our Jugni earrings are the go-to fine-dine accessory you've been looking for